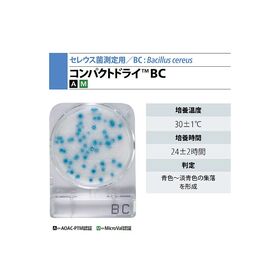

説明
【特徴】
●培地調製の不要な菌数測定用の培地です。
●MicroValを取得しています。
●接種した試料液は自然に均一に拡散します。
●発育した集落は着色するため菌数の計測が容易です。
●発育集落の釣菌が可能です。
【仕様】
●γ線滅菌済(一括包装)
●セレウス菌検出用
●入数:1箱(4枚/袋×10袋入)
●※保存方法:1~30℃(常温)
●※有効期限:製造より18ヶ月
追加情報
メーカー名:
島津ダイアグノスティクス
メーカー品番:
06533
予定納期:
注文から1~3日で発送